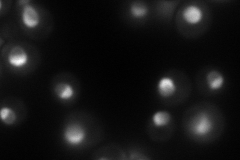
YOR206W

View description
Protein that forms a nucleolar complex with Mak21p that binds to 90S and 66S pre-ribosomes, as well as a nuclear complex with Noc3p that binds to 66S pre-ribosomes; both complexes mediate intranuclear transport of ribosomal precursors
Localization:
Intensity:
Fold change:
Significance:
-
C’ GFP library in SD

nucleolus149.86 -
N' NOP1pr-GFP in SD
nucleolus99.9688 -
N' TEF2pr-mCherry in SD

nucleus,nucleolus76.0554 -
N' NATIVEpr-GFP in SD

nucleus,nucleolus124.263 -
N' TEF2pr-VC and Cyto-VN in SD

#N/A0 -
C’ GFP library in SD+DTT

nucleolus102.610.68No -
C’ GFP library in SD+H2O2

nucleolus143.810.95No -
C’ GFP library in Starvation Media

nucleolus43.050.28Yes -
C’ GFP library on the background of Pup2-DaMP

N/A -
C’ GFP library on the background of CCT mutant

N/A0N/AYes
